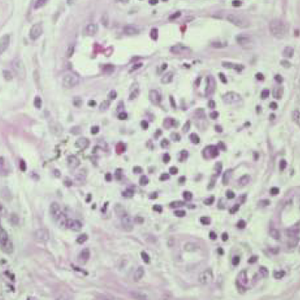

FOR AUTHORS
Search
Search Results
##search.searchResults.foundPlural##
-
Post-inflammatory hyperpigmentation after carbon dioxide laser: review of prevention and risk factors
4901PDF: 940APPENDIX 1: 142HTML: 55 -
Photoepilation and skin photorejuvenation: an update
2317PDF: 1525HTML: 669 -
-
Treatment modalities of necrobiosis lipoidica: a concise systematic review
2893PDF: 1897Suppl. Table: 441HTML: 493 -
The use of chemotherapeutics for the treatment of keloid scars
3857PDF: 1818HTML: 551 -
-
Telangiectasia Macularis Eruptiva Perstans: more than skin deep
11697PDF: 2220HTML: 2302
1 - 23 of 23 items